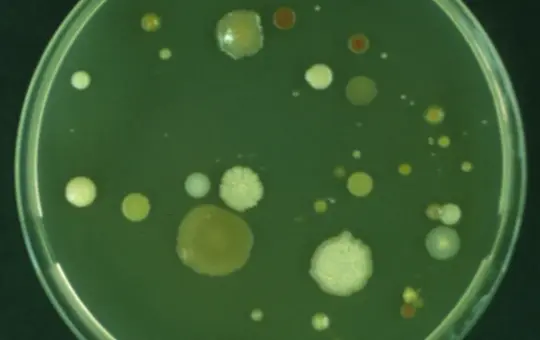

Search filter
-
- Biogeochemistry Microbiology Laboratories
- Earth Magnetic Field Models
- Earth System Modelling Data Products
- Earthquake Catalogues
- GEOFON
- Geomagnetic Observatories
- Geomorphology and Palaeoclimate Laboratories
- Gravimetric Observatories
- IAG Services
- Imaging and Spectral Facilities
- Inorganic geochemistry laboratories
- Organic Geochemistry Laboratories
- Petrophysics Laboratories
-
- GFZ
- Department 1 Geodesy
- Section 1.1 Space Geodetic Techniques
- Section 1.2 Global Geomonitoring and Gravity Field
- Section 1.3 Earth System Modelling
- Section 1.4 Remote Sensing and Geoinformatics
- Section 1.5 Space Physics and Space Weather
- Department 2 Geophysics
- Section 2.1 Physics of Earthquakes and Volcanoes
- Section 2.2 Geophysical Imaging
- Section 2.3 Geomagnetism
- Section 2.4 Seismology
- Section 2.6 Seismic Hazard and Risk Dynamics
- Department 3 Geochemistry
- Section 3.1 Inorganic and Isotope Geochemistry
- Section 3.2 Organic and Earth Surface Geochemistry
- Section 3.3 Geomicrobiology
- Section 3.4 Fluid Systems Modelling
- Section 3.5 Interface Geochemistry
- Department 4 Geosystems
- Section 4.1 Lithosphere Dynamics
- Section 4.2 Geomechanics and Scientific Drilling
- Section 4.3 Geoenergy
- Section 4.4 Hydrology
- Section 4.6 Geomorphology
- Department 5 Geoinformation
- Section 5.1 Data and Information Management
- Section 5.2 eScience Centre
-
- Archaeomagnetism
- Biogesciences
- Borehole Geopysics
- Controlled Source Seismology
- Cyberinfrastructure and Computer Sciences
- Computer Science
- Bioinformatics
- Modeling
- Cyberinfrastructure
- High Performance Computing
- Data Management/Data Services
- Earth System Modelling
- Electromagnetics
- Exploration Geophysics
- Geochemistry
- Geochronology
- Geodesy and Gravity
- Geoenergy
- Geology
- Geomorphology
- Tectonics
- Geomagnetism
- Geomagnetism and Paleomagnetism
- Geophysics
- Geodynamics
- Geoelectrics
- Petrophysics
- Geosciences
- Geothermal Energy
- Global Change
- GNSS
- Gravimetry
- Hydrogeology
- Hydrology
- Hyperspectral Remote Sensing
- Informatics
- Interdisciplinary
- Biology/Ecosystems Science
- Biogeochemistry
- Biology
- Geomicrobiology
- Microbial Studies
- Microbiology
- Laboratory Keywords
- Analytical Methods
- Computational Methods
- Visualization Methods
- Visualization
- Earth Remote Sensing Instruments
- Passive Remote Sensing
- Spectroradiometry
- In Situ/Laboratory Instruments
- Age Estimation Methods
- Tree Ring Analysis
- Bioanalytical Methods
- Culturing
- DNA Extraction
- DNA Isolation
- DNA Library Preparation
- DNA Sequencing
- Fluorescent In Situ Hybridization
- Fluorometry
- Incubation
- Next Generation Sequencing
- Polymerase Chain Reaction
- Quantitative Polymerase Chain Reaction
- Real-Time Polymerase Chain Reaction
- Chemical Meters/Analyzers
- Carbon Analysis
- Elemental Analysis
- Gas Chromatography
- Gas Chromatography Flame Ionization Detection
- High Performance Liquid Chromatography
- Ion Chromatography
- Liquid Chromatography
- Liquid Chromatography Organic Carbon Detection
- Medium Pressure Liquid Chromatography
- Pyrolysis Gas Chromatography
- Pyrolysis Gas Chromatography Flame Ionization Detection
- Total Organic Carbon Analysis
- Electrochemical Techniques
- Electrical Conductivity Measurement
- Oxygen Concentration Measurement
- pH Measurement
- Redox Potential Measurement
- Electron Diffraction
- Electron Backscatter Diffraction
- In-House Experimental Setup
- Acoustic Emission Measurements
- Analog Sandbox Experiments
- High-Temperature Creep Tests
- Shear Test
- Triaxial Deformation and Torsion Experiments
- Ultrasonic Velocity Measurements
- Material Properties
- Axial/Triaxial Test
- Coercivity
- Curie Temperature Analysis
- Demagnetization
- Magnetic Hysteresis Analysis
- Magnetic Susceptibility
- Magnetization
- Mass-Specific Magnetic Susceptibility
- Permeability
- Porosimetry
- Pycnometry
- Remanent Magnetization
- Resistivity
- Rheometry
- Ring Shear Test
- Surface Area Analysis
- Thermal Conductivity Measurement
- Viscosimetry
- Zeta-Potential Measurement
- Other Laboratory Instruments
- Particle Analysis
- Particle Size Analysis
- Photon/Optical Detectors
- Cathodoluminescence Microscopy
- Confocal Laser Scanning Microscopy
- Distributed Dynamic Strain Sensing
- Distributed Strain Sensing
- Distributed Temperature Sensing
- Fluorescence Microscopy
- Focused Ion Beam Scanning Electron Microscopy
- Laser Microdissection
- Liquid Phase Transmission Electron Microscopy
- Microscopy
- Optical Microscopy
- Photometry
- Polarization Microscopy
- Reflected Light Microscopy
- Scanning Electron Microscopy
- Transmission Electron Microscopy
- Transmitted Light Microscopy
- UV-VIS Spectrophotometry
- UV-VIS-NIR Spectrophotometry
- Probes
- Electron Microprobe Analysis
- Reactors
- Hydrothermal Synthesis
- Mineral Synthesis
- Sample Preparation
- Accelerated Solvent Extraction
- Acid Digestion
- Alkali-Fusion
- Automated Solid Phase Extraction
- Coating
- Crushing
- Desulfurization
- Drying
- Electrophoresis
- Evaporating
- Fast Solvent Extraction
- Filtration
- Fusion
- Gel Documentation
- Gel Electrophoresis
- Grinding
- Leaching
- Magnetic Extraction
- Microtomy
- Microwave Acid Digestion
- Milling
- Mineral Separation
- Polishing
- Preparation of Thin and Polished Sections
- Preparation Tephra Glass Shards
- Separation Saturated/Unsaturated Hydrocarbons
- Sieving
- Solid-Phase Extraction
- Soxhlet Extraction
- Sputtering
- Spectrometers/Radiometers
- Atmospheric Pressure Chemical Ionization
- Atmospheric Pressure Photoionization
- Brillouin Spectroscopy
- Cavity Ring Down Spectroscopy
- Electron Ionization
- Electrospray Ionization
- Elemental Analyzer Isotope Ratio Mass Spectrometry
- Fourier Transform Infrared Spectroscopy
- Fourier Transform Ion Cyclotron Resonance Mass Spectrometry
- Gas Chromatography Flame Ionization Detector Mass Spectrometry
- Gas Chromatography Isotope Ratio Mass Spectrometry
- Gas Chromatography Mass Spectrometry
- Gas Chromatography Time-of-Flight Mass Spectrometry
- High Performance Liquid Chromatography Mass Spectrometry
- High-Temperature Pyrolysis Isotope Ratio Mass Spectrometry
- Inductively Coupled Plasma Atomic Emission Spectroscopy
- Inductively Coupled Plasma Mass Spectrometry
- Isotope Ratio Mass Spectrometry
- Laser Ablation Inductively Coupled Plasma Mass Spectrometry
- Mass Spectrometry
- Matrix-Assisted Laser Desorption/Ionization
- Micro-X-Ray Fluorescence Spectroscopy
- Multicollector Inductively Coupled Plasma Mass Spectrometry
- Optical Spectroscopy
- Pyrolysis Gas Chromatography Mass Spectrometry
- Raman Spectroscopy
- Thermal Ionization Mass Spectrometry
- X-Ray Fluorescence Core Scanning
- X-Ray Fluorescence Spectroscopy
- Thermoanalytical Methods
- Differential Scanning Calorimetry
- Differential Thermal Analysis
- Pyrolysis
- Thermal Desorption Pyrolysis
- Thermogravimetric Analysis
- Thermovaporization
- X-Ray/Gamma Ray Detectors
- Energy Dispersive Analysis of X-Ray
- Laue Method
- Single Crystal X-Ray Diffraction
- Wavelength Dispersive X-Ray Spectroscopy
- X-Ray Computed Microtomography
- X-Ray Powder Diffraction
- Secondary Ion Mass Spectrometry
- Binocular Microscope
- BSE and SE Imaging
- Community-related Keywords
- Trace Element Analyses
- Cryo-Microbiology
- Cultivation
- Dendrochronology
- Density Measurement
- Depth Profiling
- Digital Image Correlation Techniques
- Element Distribution Maps
- Fluid-rock Interaction
- Geo.X Joint Lab
- High Resolution Sector Field Inductively Coupled Plasma Mass Spectrometer
- Hydrogenation
- Imaging
- Isotopic Analysis
- Laser Ablation Split Stream (LASS)-ICP-MS
- Microcosm
- Mineral Characterization
- Multi-Anvil Module
- Noble Gas Analysis
- Omics
- Particle Image Velocimetry
- Particle Search
- Petrographic Microscope
- Piston Cylinder Apparatus
- Piston Cylinder Module
- Radioisotope Tracer Study
- Sediment Preparation
- Sonic Velocity
- Stereo Microscope
- Thermophysical Properties
- Tree-ring Measurement
- UV Femtosecond Laser Ablation
- XRF Spectroscopy
- ³He and ²¹Ne Exposure Dating
- δD
- δ¹³C
- δ¹⁵N
- δ¹⁷O
- δ¹⁸O
- Life Sciences
- Magnetotellurics
- Meteorology
- Mineral Physics
- Mineralogy
- Natural Hazards
- Organic Geochemistry
- Palaeomagnetism
- Paleoclimate
- Paleogeosciences
- Paleoenvironmental Change
- Paleogeoscience
- Petrology
- Radio Occultation
- Radio Science
- Remote Sensing
- Risks
- Rock Mechanics
- Satellite Laser Ranging
- Sedimentology
- Seismic Hazard
- Seismology
- Space Geodesy
- Space Weather
- Superconducting Gravimetry
- Tectonophysics
- Volcanology
-
- Contemporary Crustal Stress
- Continuous GNSS Data
- Continuous GNSS Derived Products
- Controlled Source Seismological Data
- Earth Magnetic Field Data
- Earth Orientation Parameters
- Electric Data
- Electromagnetic Data
- Final Products
- Geomagnetic Field Models
- Geomagnetic index
- GIS
- Global Gravitational Models
- GNSS Data
- GNSS Station and Satellite Metadata
- Heat Flow Data
- Historical Earthquakes
- Magnetic Data
- Magnetotelluric Data
- Model
- Observation Data and Derived Products for the Global Navigation Satellite Systems (GNSS)
- Passive Seismological Data
- Polar Motion
- Precession/Nutation
- Precise Station Coordinates
- Processed GPS Products
- Rapid Products
- Raw Gravity and Local Pressure Records and Products
- Satellite Clock Corrections
- Satellite Data
- Satellite Orbits
- Seismic Events
- Temporal Models
- Topography Related Models
- Ultra-rapid Products
- Universal Time
AOD1B - GRACE Atmosphere and Ocean De-Aliasing Level 1B Product
The Atmosphere and Ocean De-Aliasing Level-1B (AOD1B) Product provides a priori information about temporal variations in the Earth's gravity field due to global mass variability in the Atmosphere and ocean. It is based on analysis and forecast data …
ArchKalmag14k - Correlation based model of the holocene core field, based on archeomagnetic and volcanic data
ArchKalmag14k is constructed using methods from Bayesian statistics, in particular Gaussian processes and the Kalman filter, to reflect uncertainties in data and modeling. Additionally to the field coefficients, covarianz matrices and a model ensemb…
Atmospheric and Hydrospheric Surface Loading Deformations
GFZ provides surface loading products including vertical and horizontal deformations of the crust imposed by surface loading of geophysical fluids in Atmosphere, oceans, and the continental hydrosphere. Products are provided with a spatial resolutio…
CALSxk (10.000 - 3.000 years BP) - Geomagnetic field model for the period 10.000 - 3.000 years BP
Geomagnetic field models of the last 3 to 10 kyrs based on archeo- and paleomagnetic data. This updated version of geomagnetic field description for the past 10 000 years is mainly based on the same data as CALS10k.1b. However, the model offers high…
CENEC 2008 - Mw based Earthquake Catalogue for Central, Northern and Northwestern Europe
The unified catalogue of earthquakes in central, northern, and northwestern Europe: Grünthal et al. (2009) published a catalogue for central, northern, and northwestern Europe with unified Mw for events with Mw ≥ 3.5 in the time frame 1000-2004. Thi…
CLEAR Lab "The Color of the Earth's Mantle"
Within the research group CLEAR we endeavor to understand large scale geological processes that operate deep inside planets. Our approach is to recreate high pressure-temperature conditions in the laboratory and examine various physical properties o…
CVO - Central European Volcanic Province Observatory
The primary scientific goal of the Central European Volcanic Province Observatory is to better understand and map the processes in transcrustal magma systems beneath distributed intraplate volcanic fields, and to assess their volcanic hazard and the…
DEKORP - German Continental Seismic Reflection Program
DEKORP (Deutsches Kontinentales Reflexionsseismisches Programm) was carried out between 1984 - 1997 as the German national reflection seismic program funded by the Federal Ministry of Education, Science and Technology (BMFT), now Federal Ministry of…
DEPAS | German Instrument Pool for Amphibian Seismology
The "German instrument pool for amphibian seismology" (Deutscher Geräte-Pool für amphibische Seismologie | DEPAS) provides broadband-onshore stations and ocean bottom seimometers for the preferred use within amphibious projects. The onshore componen…
Declination Calculator for the International Geomagnetic Reference Field IGRF
The declination calculator provides declination values for any location on Earth and any time between 1900 and 2025. The calculation is based on the International Geomagentic Reference Field (IGRF) which describes the geomagnetic core field. The cal…
EAM - Atmospheric and Hydrospheric Earth Rotation Excitations
The GFZ contributes to the Global Geophysical Fluid Center (GGFC) of the International Earth Rotation and Reference Systems Service (IERS) by providing matter and motion terms of effective angular momentum functions (EAM). EAMs are due to mass trans…
EMEC - The European-Mediterranean Earthquake Catalogue (Version 2021 and earlier versions)
EMEC-2021 is a catalogue of tectonic earthquakes for the broader Mediterranean area, harmonised into a single magnitude scale, Mw (Lammers, Steffi et al., 2023). It is an extended version of “The European-Mediterranean Earthquake Catalogue (EMEC) fo…
ESA ESM - the updated ESA Earth System Model for Gravity Mission Simulation Studies
The ESA ESM is a synthetic model of the time-variable gravity field of the Earth suitable for satellite gravity mission simulation studies. The model is an update of the ESA Earth System Model as described by Gruber et al. (2011), and is also given …
ElMiE-Lab - Elements and Minerals of the Earth Laboratory
The ElMiE Lab is a research-oriented facility and part of the Helmholtz center in Potsdam. The ElMiE - Lab offers the sample preparation and analyses of geological or environmental inorganic samples for element concentrations and mineralogy of inorg…
Electronic Laboratory for Geophysical Exploration Systems
The development of geophysical exploration systems with high resolution for underground applications and mobile operation on the surface implicate many interesting problems to be solved with electronics. That is, design and programming of radio-cont…
EnMAP - Scientific support of the hyperspectral satellite mission
The Environmental Mapping and Analysis Program (EnMAP) is a German hyperspectral satellite mission that monitors and characterizes the Earth’s environment on a global scale. The primary goal of EnMAP is to provide accurate diagnostic information on …
Environmental Mineralogy and Biogeochemistry Labs
The Environmental Mineralogy and Biogeochemistry Labs are an integrated laboratory suite designed for studying the formation of nature-inspired and synthetic mineral phases, and their interactions with nutrients and contaminants. This facility is th…
Experimental Simulation of Reservoir Processes (LARS)
LARS is large volume experimental apparatus for the investigation of anthropogenic induces and natural occurring reservoir processes under simulated in situ conditions in the lab. The sediment sample has a diameter of 0.45m and a length of 1.35m. Th…
FID GEO - Specialised Information Service Geosciences
The Specialised Information Service for Geosciences (FID GEO - Fachinformationsdienst Geowissenschaften) is an information service of the GFZ Helmholtz Centre for Geosciences in Potsdam (GFZ) and the Goettingen State and University Library. Funded b…
Fluvial inundation maps for the German Danube basin with future climate scenarios
This data set provides a stochastic event set of flood inundation depth maps (fluvial flood hazard footprints) for the German part of the Danube catchment for current and future climate in GEOTIFF format..
The maps provide inundation depth informati…
GE Seismic Network - GEOFON Global Seismic Network
In 2018 the GEOFON global seismic network consists of more than 80 active high quality stations with real-time acquisition. The network plays a leading role in global real-time seismology providing valuable data for almost all fundamental and applie…
GEOFON Eqinfo - GEOFON Global Earthquake Monitoring System
All real time data streams from GEOFON stations as well as around 900 additional real-time stations from international partners are used to determine rapid automatic location estimates for all globally recorded earthquakes and most regional ones. Th…
GEOFON Seismological Software
GEOFON has a long tradition of developing high-quality open software products for the seismological reasearch community. The best example is probably the SeisComP3 package (http://www.seiscomp3.org), which became one of the most widely used in the c…
GEOMAGIA50 – Paleomagnetic and Chronological Data for the Past 50 Ka
The GEOMAGIA50 database is an international collaboration to provide easy access to published archeomagnetic/volcanic and sediment paleomagnetic and chronological data for the past 50,000 years. GEOMAGIA50 has been funded by the US National Science …
GFZRNX - RINEX GNSS Data Conversion and Manipulation Toolbox
GFZRNX is a toolbox designed and created for the needs of the GNSS community. It supports RINEX observation, navigation and meteorological data. The major tasks include checking, repairing and manipulating (sampling, selection of satellite systems a…
GGF100k - Model that covers the past 100.000 years and it is the longest global reconstruction of the geomagnetic field
GGF100k is a global geomagnetic field model covering the past 100,000 years. It is the first model that provides a global view of the geomagnetic field evolution over an extended period. The model is based on an extensive global dataset of over 100 …
GGFMB - global geomagnetic field reconstruction for the period between 900,000 and 700,000 years
GGFMB is a global geomagnetic field reconstruction for the period between 900,000 and 700,000 years ago. It includes, in particular, the last complete field reversal approximately 780,000 years ago, the transition from the Matuyama chron with revers…
GGFSS70 - Geomagnetic model that covers the period of 70 - 15 kyrs, that includes 3 geomagnetic excursions
The GGFSS70 is a global geomagnetic field model covering the period 70,000 to 15,000 years ago. The model is based on nine selected sediment records from globally distributed sites. The dataset contains only high-quality paleomagnetic records, with …
GIPP | Geophysical Instrument Pool Potsdam
The "Geophysical Instrument Pool Potsdam (GIPP)" by GFZ provides seismic, magnetotelluric and geodetic instruments and sensors for projects of GFZ groups, universities and other research facilities. It is hosted by Section 2.2 | Geophysical Imaging …
GIPP-MT - Magnetotelluric component of the "Geophysical Instrument Pool Potsdam"
The magnetotelluric instruments are part of the "Geophysical Instrument Pool Potsdam (GIPP)" which means that the instruments are generally available for academic use to all German Universities. The allocation of the instruments is decided by the GF…
GONAF - Geophysical Observatory at The North Anatolian Fault
GONAF (Geophysical Observatory at the North Anatolian Fault) is a combined surface and downhole based observatory to measure tectonic deformation transients (seismic and aseismic) along the overdue Marmara segment of the North Anatolian Fault Zone (…
GRACE-C - Gravity Recovery and Climate Experiment Continuation Mission
The primary objective of the GRACE-C Mission is, as for GRACE and GRACE-FO, to obtain precise global and high-resolution models for both the static and the time variable components of the Earth's gravity field. As in the original GRACE missions, thi…
GRACE-FO - Gravity Recovery and Climate Experiment-Follow-On Mission
The primary objective of the GRACE-FO Mission is, as for GRACE, to obtain precise global and high-resolution models for both the static and the time variable components of the Earth's gravity field. As in the original GRACE mission, this goal is ach…
GeoBioLab Building (A71)
The Helmholtz Laboratory for Integrated Geoscience and Biological Research, GeoBioLab, is comprised of the Cryo-Microbiology Labs of section 3.5 and the Geomicrobiology Laboratories of section 3.3.
Geomagnetic Observatory Niemegk (NGK)
The Adolf-Schmidt-Observatory for Geomagnetism in Niemegk is operated by GFZ since 1992. It belongs to Section 2.3, Geomagnetism. The observatory is located 50km SW of Potsdam. Since 1930 it continues the measurements, that started in Potsdam in 189…
German Earthquake Zonation Map (German Building Code DIN EN 1998-1/NA-2011-01)
Service for assigning of localities in Germany (based on names or zip code) to seismic zones according to the earthquake resistant German Building Code DIN EN 1998-1/NA:2011-01, zonation map (former DIN 4149:2005-04) (only available in German and fo…
Globalwaterstorage Information Portal
The globalwaterstorage.info information portal is complementary to GravIS. While GravIS is mainly addressing scientists and students who do not necessarily have to be experts in geodesy but at least have a certain basic knowledge about GRACE/-FO or …
HELGES – Clean Laboratory for Cosmogenic Nuclides
Within HELGES, we have more than 100 m² of clean lab space is available for separation of meteoric and terrestrial cosmogenic nuclides. We prepare wide-ranging sample substrates for meteoric cosmogenic nuclides (e.g. rocks, sediments, soils, river w…
HELGES – Clean Laboratory for Stable Metal(loid) Isotopes
Within HELGES we have a ISO 6 metal-free clean laboratory, dedicated entirely to blank-sensitive metal(loid) geochemistry. Numerous ISO 4 laminar flow hoods are available for the preparation of wide-ranging sample substrates for non-traditional stab…
HELGES – Element 2 | High Resolution Inductively Coupled Plasma Mass Spectrometry (ICP-MS)
The Thermo Scientific Element 2 is a highly sensitive, high-resolution sector field inductively coupled plasma mass spectrometer. Perform accurate and reliable quantitative multi-element analyses at trace level, with the highest sensitivity and with…
HELGES – Helmholtz-Laboratory for the Geochemistry of the Earth Surface
In the HELGES Laboratory, sample preparation and measurements of cosmogenic nuclides (¹⁰Be, ²⁶Al) and stable isotopes of metals and metalloids (currently Li, Mg, Si, Fe, Sr, B) in geological and environmental sample materials, such as sediments, roc…
HELGES – Neptune | Multicollector Inductively Coupled Plasma Mass Spectrometry (MC-ICP-MS)
The main application of the Neptune MC-ICP-MS mass spectrometer is the analysis of stable and radiogenic isotope ratios of elements purified from a wide range of geological materials, including rocks, soils, plants, waters, and more. We have establi…
HELGES – Varian & Spectro | Inductively Coupled Plasma Optical Emission Spectrometer (ICP-OES)
The ICP-OES (Inductively Coupled Plasma Optical Emission Spectrometer) allows simultaneous detection and quantification of most elements in solutions at concentrations ranging from a few ng/g (ppb) to hundreds of µg/g (ppm). We analyse a wide select…
HELGES – iCAP Q | Quadrupole Inductively Coupled Plasma Mass Spectrometry (Q-ICP-MS)
To analyse element concentrations in a wide range of materials two Q-ICP-MS (iCAP Q by Thermo) are available. Samples can be analyses as solutions (e.g. water samples or rocks after acid-dissolution). Alternatively, a femtosecond laser ablation syst…
HELGOG - Helgoland Gravimetric Observatory Germany
The Helgoland Gravimetric Observatory Germany (HELGOG) was established in March 2020 in the basement of the Biologische Anstalt Helgoland (BAH) of the Alfred Wegener Institute AWI, Helmholtz Centre for Polar and Marine Research. The main research fo…
HELGOM - Helmholtz Laboratories for the Geochemistry of Organic Materials
In the Organic-geochemical Laboratories both biotic and abiotic transformation processes of sedimentary organic matter from shallow to deep, young to old, terrestrial to marine, and from molecular to basin scales are investigated.
The Organic-geoch…
HelTec - Laboratory for experimental tectonics at the GFZ Helmholtz Centre for Geosciences
Experimental tectonics is the branch of geosciences that uses so-called "analogue models" scaled down from nature to the laboratory to study tectonic processes in situ. Thanks to new materials, testing methods and monitoring techniques, which have b…
IAG Services - Services of the International Association of Geodesy (IAG Services)
The International Association of Geodesy (IAG) is the scientific organization in the field of geodesy. It promotes scientific cooperation and research in geodesy on a global scale and contributes to it through its various research bodies. It is a me…
ICDP International Continental Scientific Drilling Programme
The International Continental Scientific Drilling Program (ICDP) is a multinational program to further and fund geosciences in the field of Continental Scientific Drilling. Scientific drilling is a critical tool in understanding of Earth processes a…
ICGEM - International Centre for Global Earth Models
The determination of Earth’s global gravity field is one of the main tasks of geodesy: it serves as a reference for geodesy itself and provides essential information about the Earth, its interior and its fluid envelope for all geosciences. Thus, it …
IERS - International Earth Rotation and Reference Systems Service
The International Earth Rotation and Reference Systems Service (IERS) was established in 1987 by the International Astronomical Union and the International Union of Geodesy and Geophysics. The primary objectives of the IERS are to serve the astronom…
IGETS Database - Database of the International Geodynamics and Earth Tide Service
The International Geodynamics and Earth Tide Service (IGETS) is one of five services coordinated by the International Gravity Field Service (IFGS) of the International Association of Geodesy (IAG). The main objective of IGETS is to monitor temporal …
IPOC - Integrated Plate Boundary Observatory Chile
IPOC is an international network of institutions and scientists organising and operating a distributed system of instruments and projects dedicated to the study of the subduction system, its role in landscape evolution, and associated geohazards at …
IVS - International VLBI Service for Geodesy and Astronomy
Very Long Baseline Interferometry (VLBI) is a highly accurate technique, used since the 1970s in geodesy that has delivered groundbreaking scientific discoveries. This technique allows scientists to measure global distances with millimeter accuracy;…
KTB - German Continental Scientific Deep Drilling Programme In Windischeschenbach, Germany (Kontinentale Tiefbohrung)
The Continental Deep Drilling Program of Germany (in German: Kontinentales Tiefbohrprogramm der Bundesrepublik Deutschland, abbreviated as KTB) was a scientific drilling project near the town of Windischeschenbach, Bavaria. The KTB Depth Laboratory …
LSMOD Models - Models for the periode of 30 to 50 kyrs that contain the Laschamp and Mono Lake field excursions
Geomagnetic field models for the periode of 30 to 50 kyrs that contain the Laschamp and Mono Lake field excursions. The LSMOD models (current version LSMOD.2) represent the global evolution of the geomagnetic field for the time interval 50 to 30 ka.…
MGEX - Analysis Center of the Multi-GNSS Experiment
The Multi GNSS Experiment (MGEX) was initiated by the IGS in 2012. In MGEX all available signals of the new GNSS satellites are analysed. Currently, seven IGS analysis centers generate consistent and precise orbits and clock corrections of the new s…
Mag.num - Model of the geomagnetic core field, based on satellite and observatory data
Mag.num models are the series of recent GFZ high-precision geomagnetic core field models that rely on satellite magnetic field measurements, in particular on calibrated Swarm and CHAMP vector field and ground observatory data. The coefficients of th…
MuSPIS - Multiple Sample Production and Injection Simulator
The experimental task is to realize controlled long-term investigations on the permeability evolution of sedimentary rocks at simulated pressure- and temperature conditions pertinent to geothermal reservoirs.
Therefore, the investigations are perf…
OSG ICDP | Operational Support Group of the International Continental Scientific Drilling Program
The Operational Support Group of the International Continental Scientific Drilling Program, ICDP, situated at GFZ, provides downhole logging services and access to utilize the ICDP instrument pool for PIs of successful ICDP proposals. ICDP is a prop…
PISA – FEI Tecnai Transmission Electron Microscopy Laboratory (TEM)
The Transmission Electron Microscopy TEM laboratory is a state-of-the-art facility equipped with a FEI Tecnai G2 F20 X-Twin transmission electron microscope and a FEI FIB200TEM Focused Ion Beam device for specimen preparation. The laboratory provide…
PISA – Liquid Phase-(Scanning) Transmission Electron Microscopy (LP-(S)TEM)
Liquid Phase-(Scanning) Transmission Electron Microscopy (LP-(S)TEM) allows in situ observations of the dynamic behaviour of materials in liquids, with both high spatial resolution and temporal resolution. In LP-(S)TEM, the liquid cell is mounted at…
PISA – Potsdam Imaging and Spectral Analysis Facility
The PISA facility combines the state-of-the-art imaging and spectral technologies for all kinds of research applications. It consists of a range of electron microscopes with various detectors including EBSD and EDS, and optical microscopes.
High-re…
PISA – ZEISS Ultra Plus Scanning Electron Microscope (SEM)
The Field Emission-Scanning Electron Microscope of the Zeiss Ultra Plus allows you to capture, analyze and supplement high-resolution images to get total information out of your sample. The complete detection system of the Ultra Plus combines a high…
Permanent Magnetotelluric Reference Station in Wittstock, Germany
The sources for the magnetotelluric (MT) method are naturally occurring electromagnetic field variations. Electromagnetic currents are excited over a wide frequency range in the earth’s ionosphere by solar activity and global lighting discharges. Wh…
Radiance Light Trends
Radiance Light Trends is a GIS web application that is designed to quickly display information about radiance trends at a specific location (available online at https://lighttrends.lightpollutionmap.info). It uses data from two satellite systems, DM…
SHEEC - the SHARE European Earthquake Catalogue 1900-2006
The SHARE European Earthquake Catalogue (SHEEC) 1900-2006 has been compiled by GFZ Potsdam in the frame of an independant project and represents a temporal and spatial excerpt of "The European-Mediterranean Earthquake Catalogue" (EMEC) for the last …
SMARTIES - Supercritical fluids and MAgma Reconnaissance for Transformative Iceland Energy Solutions
Recognizing that the exploration and harnessing of magmatic and geothermal reservoirs involves many disciplines, the mission of “SMARTIES” is to implement a long-term observatory facility together with episodic field experiments for defining, testin…
Satellite Receiving Station Ny-Ålesund (Spitsbergen)
The GFZ Helmholtz Centre for Geosciences operates a satellite receiving station at Ny-Ålesund, Spitsbergen (78° 55´ North, 11° 56´ East) to receive data from research satellites in polar orbits. The station is located about 1 km outside the village,…
Stable Isotope Laboratory for Sediments and Water
In the laboratories for stable isotopes in sediments and water, the isotope ratios of the light elements nitrogen (N), carbon (C) and oxygen (O) in continental geoarchives such as lake sediments and speleothems as well as oxygen (O) and hydrogen (H)…
TERENO-NE - Northeastern German Lowland Observatory
The Northeastern German Lowland observatory (TERENO-Northeast) is part of the Helmholtz Association`s interdisciplinary, long-term research network of Terrestrial Environmental Observatories - TERENO representing typical landscapes in Central Europ…
TIGA - Processing Center of the Tide Gauge Benchmark Monitoring Working Group
Being a modern geodetic measuring method, GNSS (Global Navigation Satellite Systems) has reached an important role in geosciences. Within the scope of the Tide Gauge Benchmark Monitoring Working Group (TIGA-WG) of the IGS, GFZ analyses and reprocess…
CHAMP - CHAllenging Minisatellite Payload inactive
CHAMP (CHAllenging Minisatellite Payload) was a German small satellite mission for geoscientific and atmospheric research and applications, managed by GFZ. With its highly precise, multifunctional and complementary payload elements (magnetometer, ac…
GOCE - Gravity Field and Steady-State Ocean Circulation Explorer inactive
The Earth explorer satellite GOCE (Gravity Field and Steady-State Ocean Circulation Explorer) was the first satellite mission within the framework of the Living Planet Program of ESA. This satellite mission was mapping the Earth's gravity field on g…
GRACE - Gravity Recovery and Climate Experiment inactive
GRACE was a joint project between the National Aeronautics and Space Administration (NASA) and the Deutsches Zentrum für Luft- und Raumfahrt (DLR). The mission has been proposed in 1996 jointly by the University of Texas at Austin, Center for Space …